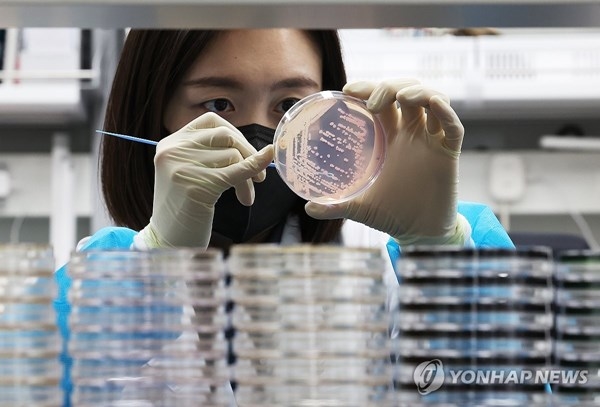

충북 진천군에서 열린 생거진천문화제(25∼28일) 기간 중 축제장 내 식당에서 식사한 주민 다수가 집단 식중독 증세를 보여 당국이 원인 조사에 나섰다.
29일 진천군에 따르면 지난 27일 축제장에 마련된 한식 뷔페를 먹은 주민들이 구토와 설사 등 식중독 증세를 호소했다.
전날 28일 오후 6시 기준 161명이 식중독 의심 증상을 보였으며, 이후 증상자가 늘어 이날 현재 환자는 170명으로 집계됐다.
진천군은 이들의 가검물을 채취해 충북도보건환경연구원에 정밀검사를 의뢰하는 한편 수인성감염병 대책반을 편성했다.
(사진=연합뉴스)
한국경제TV 디지털뉴스부 김현경 기자
khkkim@wowtv.co.kr관련뉴스








